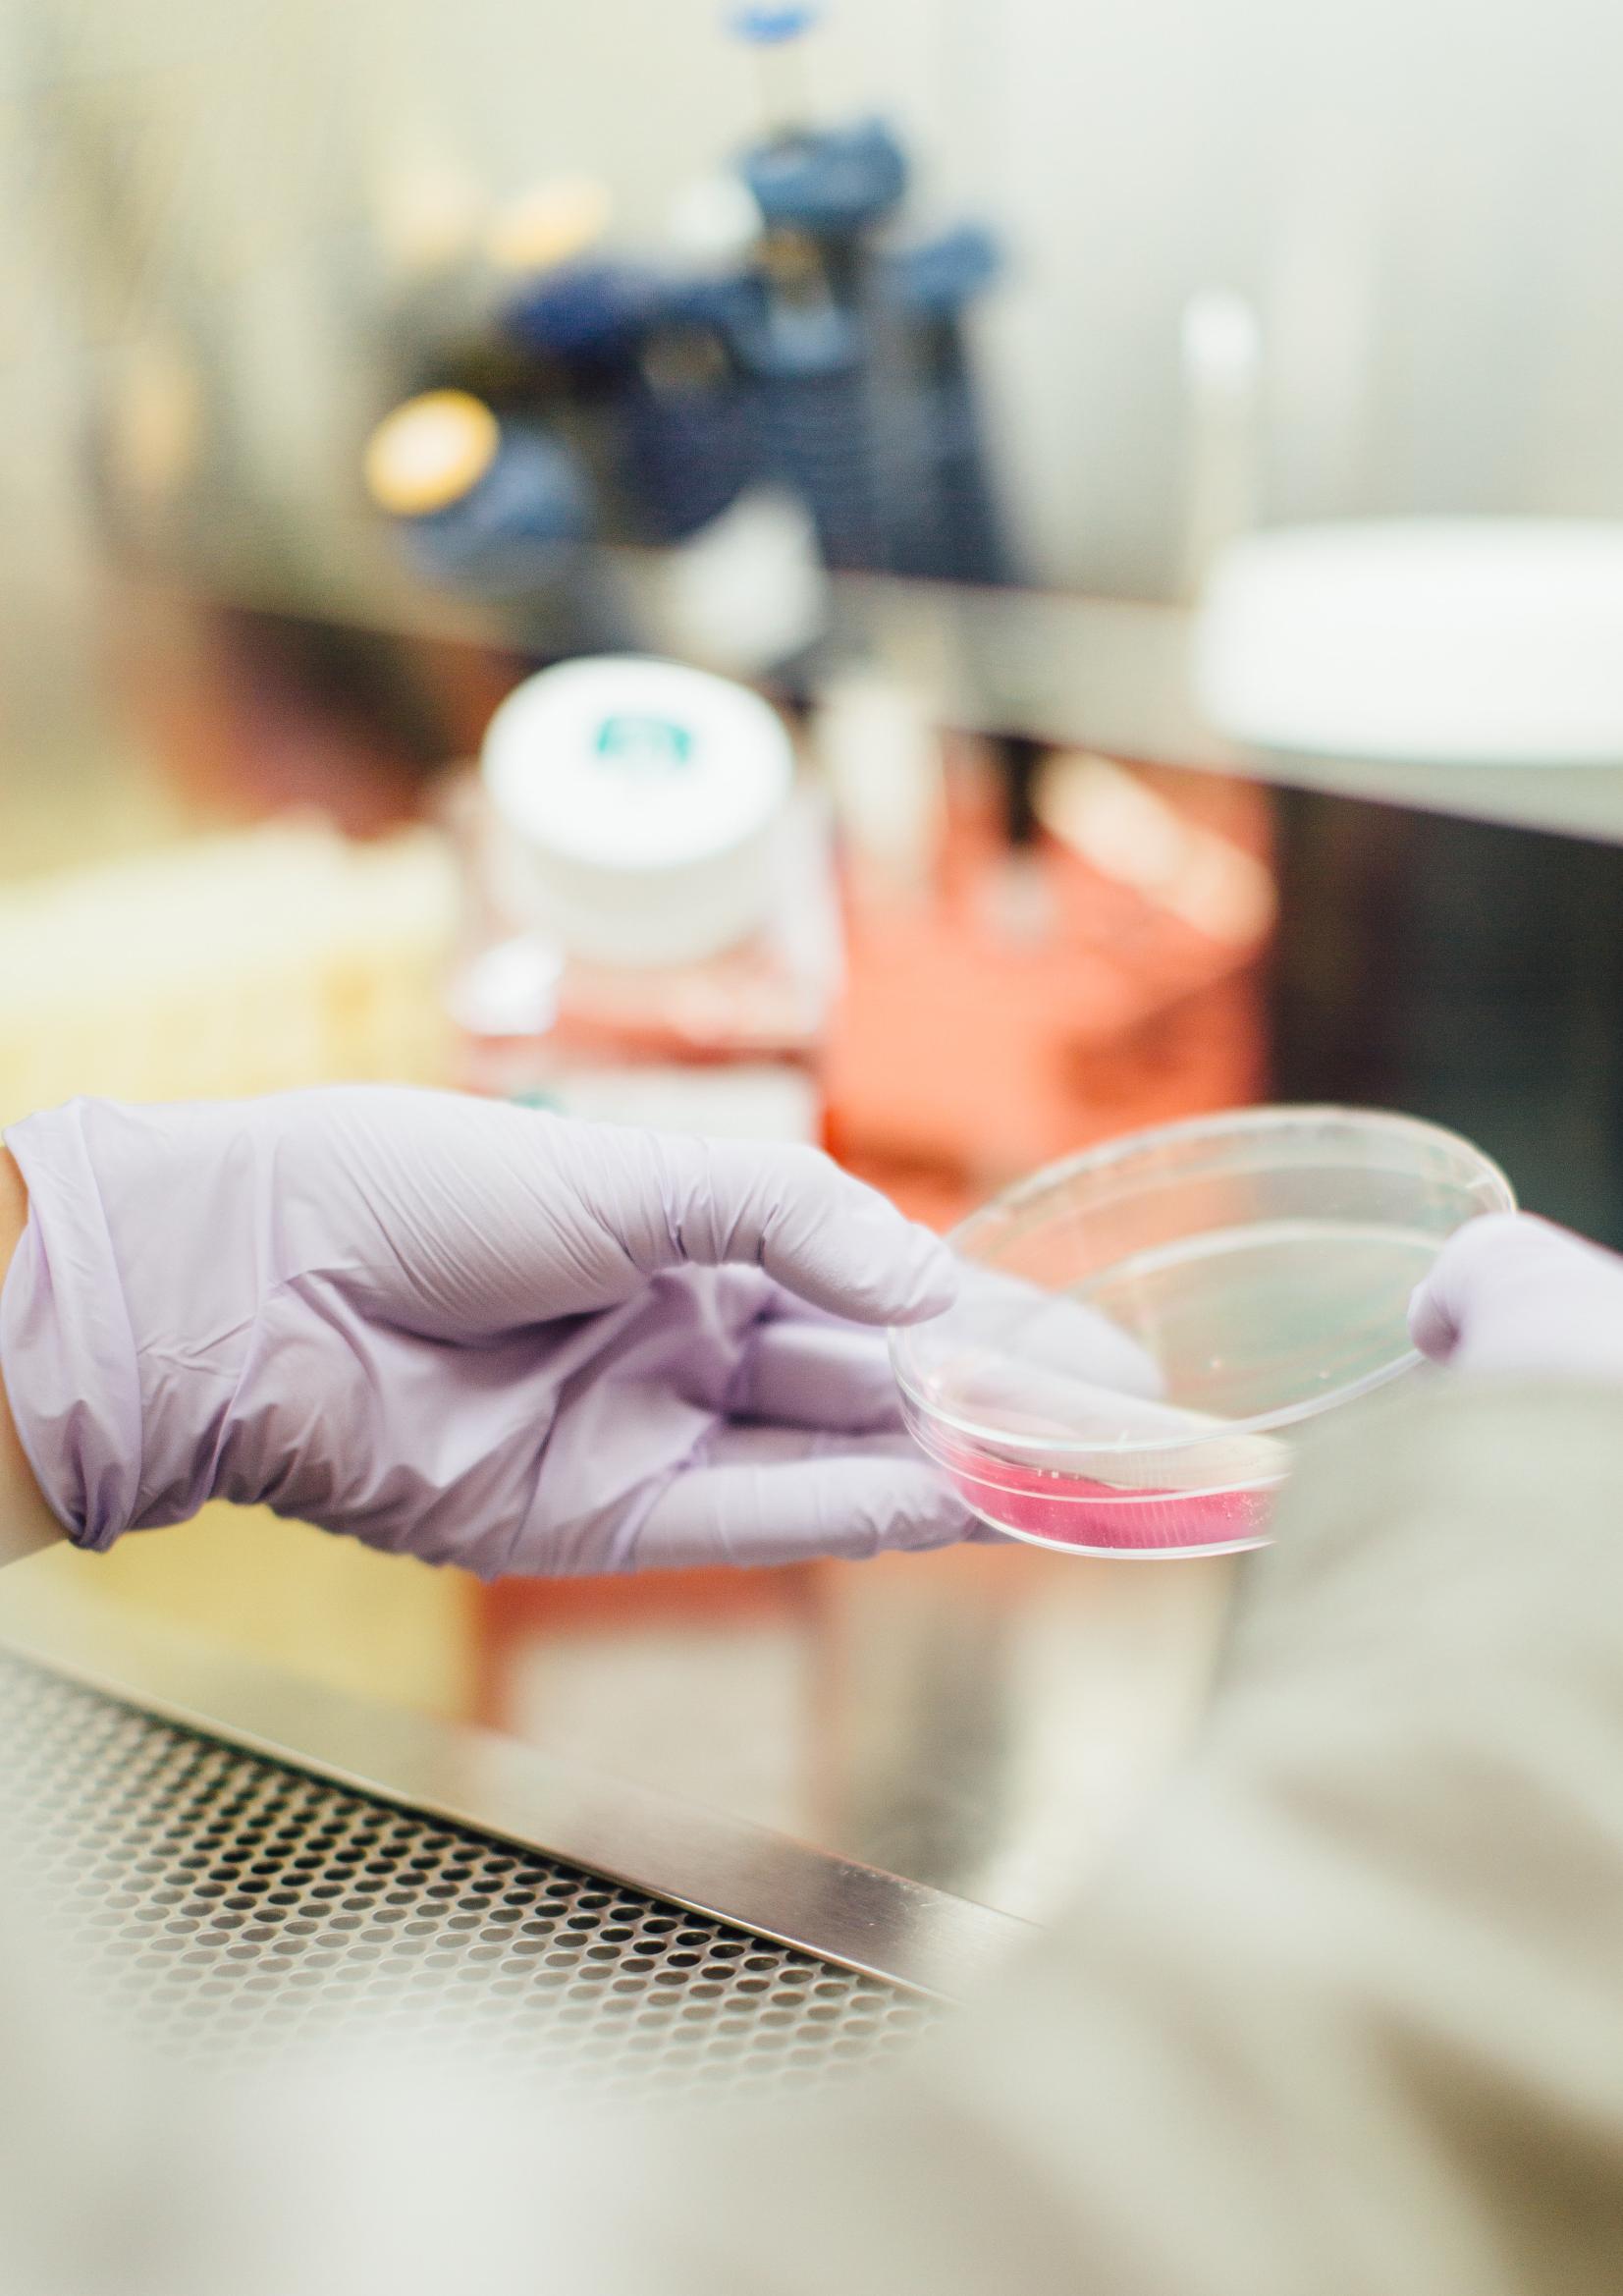

OUR HEALTH & LIFE SCIENCE EXPERIENCE

![]()



Founded in 1992, the company has grown from strength to strength, seeing the team expand at its Northampton headquarters, and the acquisition of a Birmingham and Bristol office The ownermanaged firm is led by seven Partners, supported by an experienced team of project managers, project surveyors, building surveyors, and technical administrators.
Our team is what sets us apart, alongside our commitment to delivering an outstanding service on every project we work on. With expertise from client and contractor backgrounds, our workforce ranges in experience levels, enabling us to fit the right team for your job.
We aim to provide our clients with dedicated experts to support the smooth and successful delivery of your vision, from conception to completion and beyond, through the following core service lines:
• Project Management
• Employer’s Agent
• Quantity Surveying
• Building Consultancy
• Principal Designer
Reliability and flexibility are key to any successful project, which is why we adopt a forwardthinking, proactive approach to our work, supported by our industry knowledge, ongoing research and benchmarking of current market trends.
In addition to our core services noted above, we also offer the following supplemental services:
• Dilapidations
• Building Survey
• Licence to Alter
• Party Wall
• Clerk of Works, or Quality Monitoring
• Fund Monitoring
• Facilities and Property Management
We are proud to have developed strong repeat partnerships with our clients, some of which span over the 30 years we have been in business. Our enviable position as experts in industrial, commercial, and education sectors has enabled us to enter new areas such as retail, retirement living, infrastructure, hotel, life science, and occupier fitout. Our people and portfolio of work allow us to provide invaluable insight across a variety of industry sectors.

We have an incredibly strong team of experienced project managers, who are responsible for the successful delivery of your construction project. Working closely with our clients, the team are well equipped to organise, control, and monitor ongoing construction operations. In addition to our project management team, we have a strong and capable technical administration department, which ensures all crucial paperwork is completed. We pride ourselves on the hands-on leadership and guidance we offer, from pre-commencement to completion.
The quantity surveying team’s strengths lie in their diverse backgrounds within client organisations, professional practice and contracting. This breadth of exposure enables us to offer broad skillsets and experience on all projects across our sectors.
Our technical administration department provides additional support to the surveying team, ensuring the work produced is issued promptly and of the highest quality
With our team’s collective industry expertise, combined with a wealth of benchmarking data we acquire from our live projects, we can provide our clients with recommendations that accurately align with the changing business landscape.
In addition, we have access to RICS Membership, BCIS data, CostX measurement software and JCT online, whilst actively supporting quantity surveying apprenticeships with Nottingham Trent University, allowing us to continue onboarding new talent for the future of construction.

As employer’s agent, we ensure the project is structured correctly and that the investment value of the scheme is protected. As well as representing our client, we will administer the contract and complete all appointments, warranties, and other key legal documents, alongside organising, chairing, and recording meetings / key events.
We are there to support, advise and organise our clients. Depending on the requirement the role will be fulfilled by one of our senior project managers or project surveyors, with backup support from the wider technical team.
As a business, we have invested heavily in training key members of the project management team as principal designers. As members of the APS, Association for Project Safety, we are competent in influencing how risks to health and safety are managed throughout the project.
When appointed as project managers on a scheme, we can extend our appointment to include principal designers where required.
The breadth of experience within our professional team means that we have worked across all property sectors, which allows us to provide our clients with detailed and reliable advice across the full property life cycle.
We understand our client’s requirements, working seamlessly to provide proactive advice on a range of technical issues, including acquisition surveys and fund monitoring reporting, technical due diligence, landlord and tenant dilapidations claims, planned preventative maintenance, party wall matters, together with building refurbishment and fit out project management and contract administration services for projects of all shapes and sizes.
It is our professional team’s experience, knowledge, understanding and logical, lateral thinking that affords us the ability to provide the accurate, timely and focused advice our clients expect.

Goodrich’s benchmarking data is solely based on contract data, thereby ensuring that only realworld information is used when compiling the benchmark ranges. The use of ‘real life’ contract data, rather than estimates or contractors’ cost plans, better reflects the fluctuations in materials, labour and rates. The data is continuously updated; this is undertaken on each contract sum analysis and only once the contract is awarded.
We understand that accurate cost information is paramount to allow our clients to have the confidence to make informed decisions throughout key project stages We have collated over 6 years of detailed I&L cost data, encompassing 13.33 million sq ft and just over £1 billion in combined value.
We have provided cost advice on a wide variety of building types ranging from £100k to £100m, and everything in between.



We work for both Landlords and Tenants, preparing schedules of dilapidations for Landlords and responding to schedules on behalf of Tenants. Our experienced team reviews all the legal documentation in preparing/responding to schedules, inspecting the demise for breaches under the terms of the lease and conducting negotiations to conclude the claim in accordance with the lease terms.
We also provide consultancy advice on dilapidation strategies including assessment of liability and obligations in preparation of lease events.
Our team of building consultants can carry out a detailed inspection and report on the structure and fabric of the property together with comments on the condition of the services, predominantly for the owner/occupiers. The report will also recommend additional specialist inspections and reports as required, i.e. services, environmental, deleterious materials, DDA, etc.
We will conduct a technical review of a tenant/occupier’s proposed works to assess the suitability of information received and compliance with Lease Terms or Covenants. Comment upon the impact on the structure and fabric of the property, and on the statutory and legal compliance of the proposed works. The report will also provide advice on reinstatement requirements to be considered for inclusion with any formal Licence to Alter.
We will manage negotiations on behalf of the building owner or adjoining owner of the terms and conditions applicable where works are affecting a party wall, having due regard to the Party Wall etc. Act 1996.

We recognise the importance of quality when it comes to building. That’s why we have a mix of experts, many with building surveying and on-site backgrounds, who are placed to provide a constructive view on the quality and appropriateness of your built asset as the works progress.
We have provided fund monitoring services to Barwood Capital, NatWest, Octopus and Handelsbanken for a variety of building projects. We are practical and realistic, providing guidance and advice as the project progresses from the agreement of funding through to completion.
We can care for your asset as part of our facilities and property management services, in a way that suits your business.
Covering all services from a soft-landing handover to operators and occupiers, management and provision of all hard and soft facilities services to the asset and occupiers, management of all operational health and safety compliance, budget and financial management, and reactive services management.
Our consultative services available include property operating budgets, services charge advice, operating lifecycle plans and operational best practice advice.









At Goodrich, we understand the importance of being strategic in our approach to social responsibility We’re committed to raising awareness of both our individual and collective impact on the planet.
In partnership with Planet Mark, we gather and analyse key data across our business to gain valuable insight into our carbon footprint. This helps us identify the areas where change is most needed and where we can make the biggest difference With this knowledge, we can make informed decisions that drive meaningful improvements, not just within our business, but in the wider community too.
Reducing our environmental footprint is a responsibility we take seriously We are focused on taking proactive, forward-thinking steps that support positive change for the planet and society, helping to build a more sustainable future for all.
As our business continues to grow, we recognise that balancing progress with sustainability presents its challenges. However, we remain committed to exploring new initiatives that help us meet our carbon reduction goals.
Each year, we report on our performance across the following key categories:
Scope 1
The emissions from sources that a company creates directly.
Scope 2
The emissions a company creates indirectly, associated with the energy it purchases
Scope 3
The emissions that are not produced by the company itself, but by those within the company’s value chain.
Our teams also play a vital role in driving our CSR efforts. Every year, each team is encouraged to support their local communities, schools, and charities by organising at least two CSR events to encourage a culture inspired by involvement and impact.
Developments of this nature are incredibly unique and can be very complex due to the regulations and standards that need to be met.
It is imperative that R & D centres meet the strict requirements for cleanliness, and provide a sterile, safe environment for patients and staff to enable them to carry out invaluable research, production, and distribution. As a relatively new and evolving sector, we enjoy the challenges that it brings.
We are excited to be working on several life science projects, but due to the nature of the work, we are unable to share further details due to project confidentiality.
Project Name:
Client Name:
Project Details:
Project Address/ Postcode:
Project Value:
Contract Duration:
Key Facts:



Bicester Gateway
Bloombridge Development Partners
12 ‘Knowledge Economy’ Units in Use Class E. 14,972 m2 (161,157 sq ft)
Bicester Gateway, Oxfordshire OX 25 2PA
£20 million
The project is currently Pre-Contract. The planning decision was received on the 11th of November 2022.
The proposals specifically target the Knowledge Economy market with specific features of the buildings, including:
• Enhanced elevational treatments
• Increased power supply
• Planning for flues/louvres to be obtained with the base build application
• A higher percentage of base build office space
• A roof level plant deck with capacity for Cat B plant to suit a laboratory occupier
• BREEAM ‘Excellent’
• Standalone swift tower to suit the local ecology, without compromising the appearance of the buildings

Project Name:
Client Name:
Client Overview:
Project Overview:



Mars is a global, family-owned business committed to innovation and making a positive impact worldwide. With a diverse portfolio spanning snacking, food, and pet care products, the company’s portfolio includes some of the world’s most renowned brands such as Ben’s Original , CESAR®, DOVE®, M&M’s®, SNICKERS®, PEDIGREE®, and WHISKAS®. In addition to its consumer products, Mars is advancing pet health through its global network of pet hospitals and diagnostic services, including AniCura, BANFIELD , BLUEPEARL , Linnaeus, and VCA leveraging cutting-edge technology to lead breakthroughs in genetic health screening and DNA testing, all aimed at creating a better world for pets.



Waltham is the global centre for pet health research within Mars and extensively collaborates with multiple external partner organisations worldwide. As a visitors' centre, it attracts around 2500 people annually, making it a significant part of the project. This is reflected in the aesthetics of the scheme, with its extensive landscaping and greenspaces.
The approximately 107-acre site located in rural Leicestershire close to the village of Waltham-on the-Wolds was originally a stud farm purchased by the business with the vision of creating a dedicated pet research facility.
Goodrich Consulting is acting as the lead consultant, project manager and quantity surveyor with the design team under its direct control. This allows us to provide the client with a single point of contact who is responsible for the overall delivery of the master planning and planning applications.
This is a 10-15 year scope and will incorporate the creation of new and replacement of dated facilities, ensuring the necessary infrastructure and open landscaped spaces fully reflect the requirements of our client.
This is a highly technical and flexible scheme which will require the team to work closely alongside Mars on a long-term delivery programme


Project Name:
Client Name:
Project Details:
Project Address:
Project Value:
Contract Duration:
Key Facts:

St Andrew’s Healthcare

This was a fast-track programme refurbishment of existing specialist mental health units within the Cliftonville campus whilst in occupation
Cliftonville, Northampton
£1.5 million
Fast-track within an occupied unit
We provided project and cost management services on this fast-track refurbishment project. Whilst the work itself was relatively simple, the products and specification of the material were highly sensitive.
This, alongside the occupied nature of the unit, made the project complex and a challenge to deliver within the parameters set. Despite this complexity, we managed the scheme through to a successful completion with R G Carter as the general builder.
